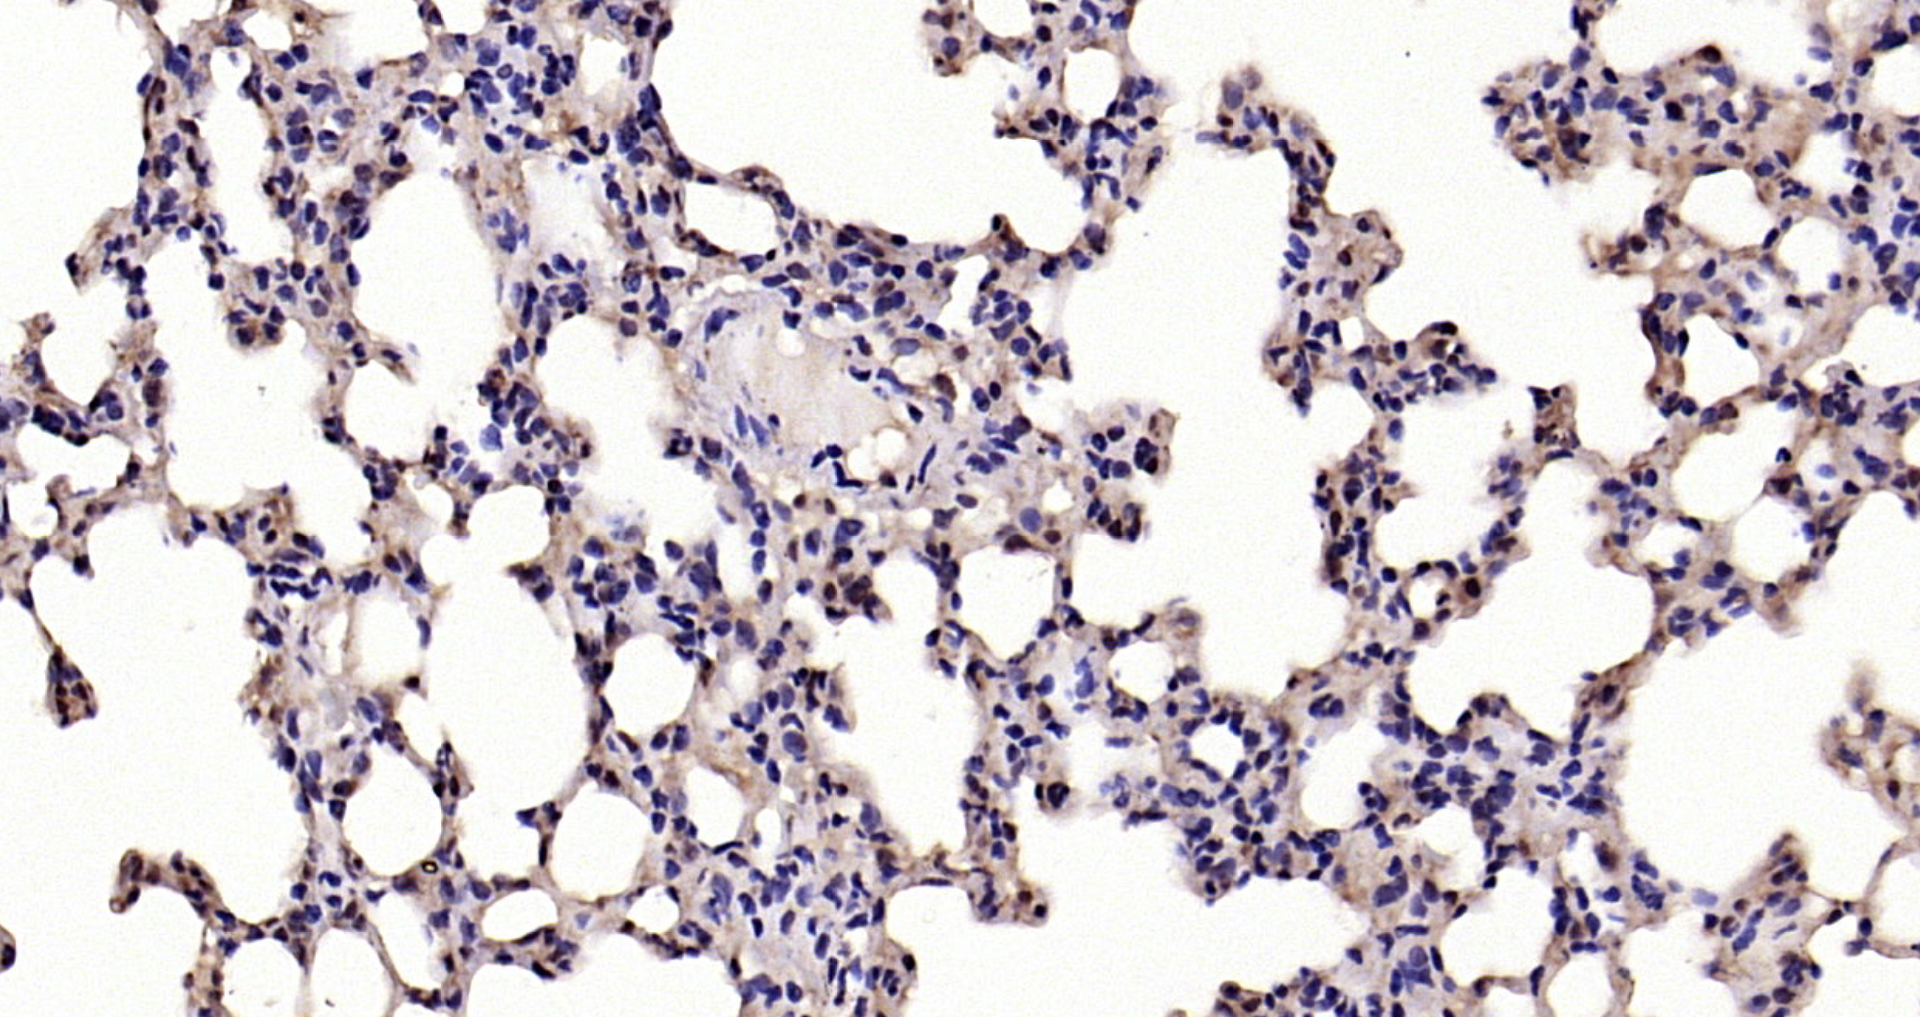
Paraformaldehyde-fixed, paraffin embedded Mouse lung; Antigen retrieval by boiling in sodium citrate buffer (pH6.0) for 15min; Block endogenous peroxidase by 3% hydrogen peroxide for 20 minutes; Blocking buffer (normal goat serum) at 37°C for 30min; Antibody incubation with NFKBIA/IKB alpha Polyclonal Antibody, Unconjugated (bs-1287R) at 1:200 overnight at 4°C, DAB staining.

Lane 1: Mouse Spleen lysates probed with NFKBIA/IKB alpha Polyclonal Antibody, Unconjugated (bs-1287R) at 1:300 overnight at 4˚C. Followed by a conjugated secondary antibody at 1:10000 for 60 min at 37˚C.
IKB alpha Polyclonal Antibody
BS-1287R
ApplicationsFlow Cytometry, ImmunoFluorescence, Western Blot, ELISA, ImmunoCytoChemistry, ImmunoHistoChemistry, ImmunoHistoChemistry Frozen, ImmunoHistoChemistry Paraffin
Product group Antibodies
TargetNfkbia
Overview
- SupplierBioss
- Product NameIKB alpha Polyclonal Antibody
- Delivery Days Customer16
- ApplicationsFlow Cytometry, ImmunoFluorescence, Western Blot, ELISA, ImmunoCytoChemistry, ImmunoHistoChemistry, ImmunoHistoChemistry Frozen, ImmunoHistoChemistry Paraffin
- Applications SupplierWB(1:300-5000), ELISA(1:500-1000), FCM(1:20-100), IHC-P(1:200-400), IHC-F(1:100-500), IF(IHC-P)(1:50-200), IF(IHC-F)(1:50-200), IF(ICC)(1:50-200)
- CertificationResearch Use Only
- ClonalityPolyclonal
- Concentration1 ug/ul
- ConjugateUnconjugated
- Gene ID18035
- Target nameNfkbia
- Target descriptionnuclear factor of kappa light polypeptide gene enhancer in B cells inhibitor, alpha
- Target synonymsNfkbi, NF-kappa-B inhibitor alpha, I(Kappa)B(alpha), I-kappa-B-alpha, I-kappaBalpha, ikB-alpha, ikappaBalpha, nuclear factor of kappa light chain gene enhancer in B-cells inhibitor, alpha, nuclear factor of kappa light polyp gene enhancer in B-cell 1
- HostRabbit
- IsotypeIgG
- Protein IDQ9Z1E3
- Protein NameNF-kappa-B inhibitor alpha
- Storage Instruction-20°C
- UNSPSC12352203
References
- Wang M, Yan S, Zhou Y, et al. trans-Cinnamaldehyde Reverses Depressive-Like Behaviors in Chronic Unpredictable Mild Stress Rats by Inhibiting NF-κB/NLRP3 Inflammasome Pathway. Evid Based Complement Alternat Med. 2020,2020:4572185. doi: 10.1155/2020/4572185Read this paper
- Peng LY, Yuan M, Shi HT, et al. Protective Effect of Piceatannol Against Acute Lung Injury Through Protecting the Integrity of Air-Blood Barrier and Modulating the TLR4/NF-κB Signaling Pathway Activation. Front Pharmacol. 2019,10:1613. doi: 10.3389/fphar.2019.01613Read this paper
- Zhou J, Liu Q, Qian R, et al. Paeonol antagonizes oncogenesis of osteosarcoma by inhibiting the function of TLR4/MAPK/NF-κB pathway. Acta Histochem. 2020,122(1):151455. doi: 10.1016/j.acthis.2019.151455Read this paper
- Han X, Dong XX, Shi MY, et al. SUMOylation and deacetylation affect NF-κB p65 activity induced by high glucose in human lens epithelial cells. Int J Ophthalmol. 2019,12(9):1371-1379. doi: 10.18240/ijo.2019.09.01Read this paper
- Fang D, Lai Z, Wang Y. Overexpression of Biglycan is Associated with Resistance to Rapamycin in Human WERI-Rb-1 Retinoblastoma Cells by Inducing the Activation of the Phosphatidylinositol 3-Kinases (PI3K)/Akt/Nuclear Factor kappa B (NF-κB) Signaling Pathway. Med Sci Monit. 2019,25:6639-6648. doi: 10.12659/MSM.915075Read this paper
- Xin H, Wang C, Liu Z. miR-196a-5p promotes metastasis of colorectal cancer via targeting IκBα. BMC Cancer. 2019,19(1):30. doi: 10.1186/s12885-018-5245-1Read this paper
- Li Y, Zhao W, Wang H, et al. Silencing of LncRNA steroid receptor RNA activator attenuates polycystic ovary syndrome in mice. Biochimie. 2019,157:48-56. doi: 10.1016/j.biochi.2018.10.021Read this paper
- Ma M, Pei Y, Wang X, et al. LncRNA XIST mediates bovine mammary epithelial cell inflammatory response via NF-κB/NLRP3 inflammasome pathway. Cell Prolif. 2019,52(1):e12525. doi: 10.1111/cpr.12525Read this paper
- Zou P, Ji HM, Zhao JW, et al. Protective effect of isoliquiritigenin against cerebral injury in septic mice via attenuation of NF-κB. Inflammopharmacology. 2019,27(4):809-816. doi: 10.1007/s10787-018-0503-zRead this paper
- Gong J, Guan L, Tian P, et al. Rho Kinase Type 1 (ROCK1) Promotes Lipopolysaccharide-induced Inflammation in Corneal Epithelial Cells by Activating Toll-Like Receptor 4 (TLR4)-Mediated Signaling. Med Sci Monit. 2018,24:3514-3523. doi: 10.12659/MSM.907277Read this paper